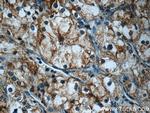
FAM92A1 Antibody in Immunohistochemistry (Paraffin) (IHC (P))

Search
Proteintech
FAM92A1 Polyclonal Antibody
{{$productOrderCtrl.translations['antibody.pdp.commerceCard.promotion.promotions']}}
{{$productOrderCtrl.translations['antibody.pdp.commerceCard.promotion.viewpromo']}}
{{$productOrderCtrl.translations['antibody.pdp.commerceCard.promotion.promocode']}}: {{promo.promoCode}} {{promo.promoTitle}} {{promo.promoDescription}}. {{$productOrderCtrl.translations['antibody.pdp.commerceCard.promotion.learnmore']}}
产品信息
24803-1-AP
种属反应
已发表种属
宿主/亚型
分类
类型
抗原
偶联物
形式
浓度
规格
纯化类型
保存液
内含物
保存条件
运输条件
产品详细信息
Immunogen sequence: ATLTARNRE AKQLTQLERT RQRNPSDRHV ISQAETELQR AAMDASRTSR HLEETINNFE RQKMKDIKTI FSEFITIEML FHGKALEVYT AAYQNIQNID EDEDLEVFRN SLYAPDYSSR LDIVRANSKS PLQRSLSAKC VSGTGQEAGW AATCQTLI (162-318 aa encoded by BC014598)
靶标信息
Acts as a positive regulator of ciliary hedgehog signaling. Probable regulator of ciliogenesis involved in limb morphogenesis. In cooperation with CBY1 it is involved in the recruitment and fusion of endosomal vesicles at distal appendages during early stages of ciliogenesis. [UniProt]
仅用于科研。不用于诊断过程。未经明确授权不得转售。
生物信息学
蛋白别名: CBY1-interacting BAR domain-containing protein 1; family with sequence similarity 92 member A; family with sequence similarity 92 member A1; protein FAM92A; protein FAM92A1; unnamed protein product
基因别名: BARMR1; CIBAR1; FAM92A; FAM92A1; PAPA9
UniProt ID: (Human) A1XBS5
Entrez Gene ID: (Human) 137392